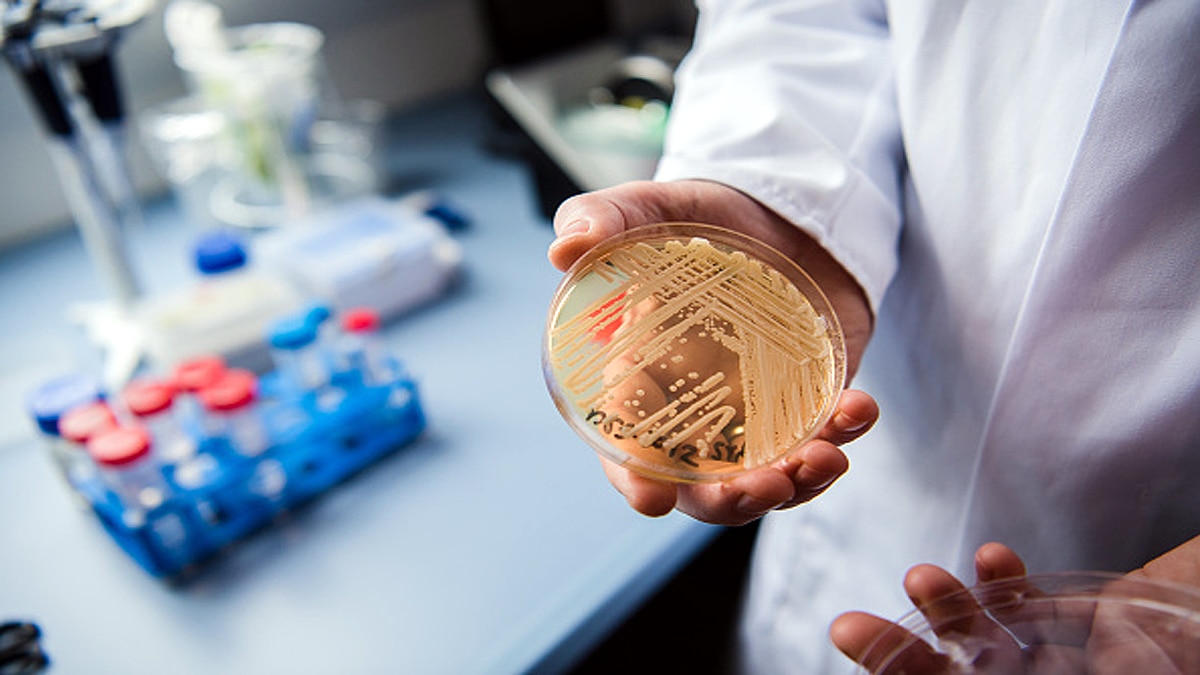
Deadly Hospital Superbug on Andaman Island
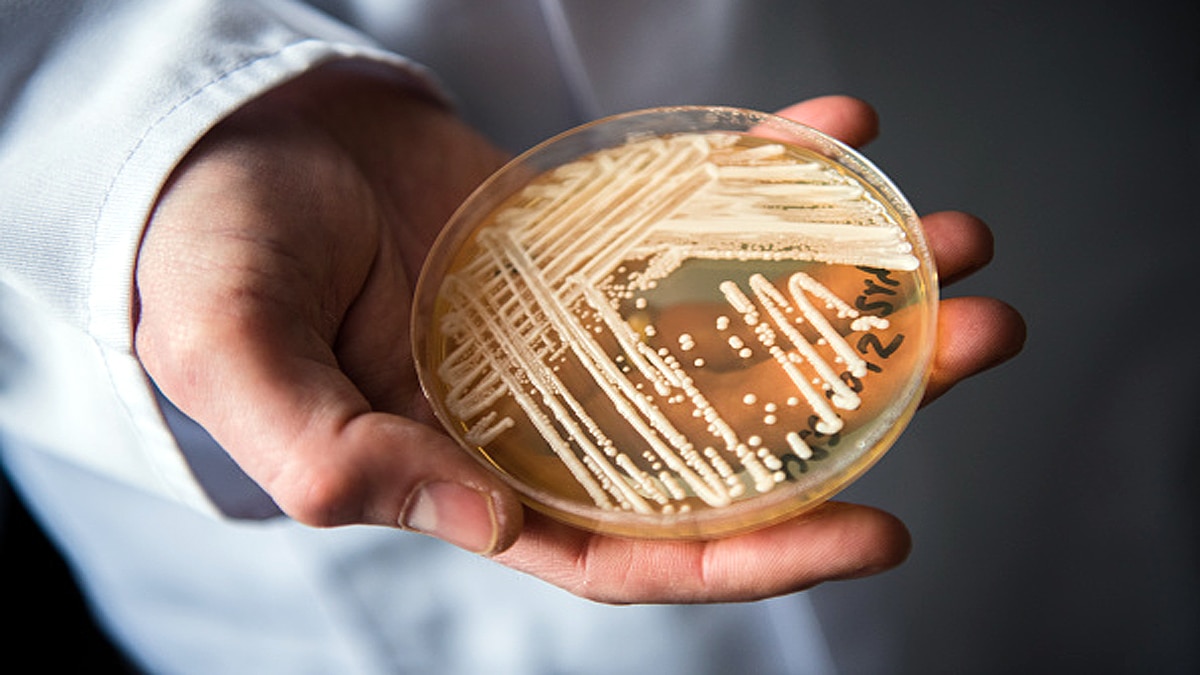
Deadly Hospital Superbug in Andaman Island

डरावना खुलासा- अंडमान-निकोबार द्वीप पर खुले में घूम रहा घातक सुपरबग, कई दवाओं से बच सकता है
अंडमान और निकोबार द्वीप समूह के एक दूरस्थ द्वीप पर खतनाक और जानलेवा हॉस्पिटल सुपरबग मिला है. यह मल्टीड्रग-रेसिसटेंट ऑर्गेनिज्म है. यानी इस पर कई दवाओं का असर नहीं होता. हैरानी की बात ये है कि पहली बार शोधकर्ताओं को ये सुपरबग खुले में मिला है. ये खुलासा किया है बाल्टीमोर स्थित जॉन्स हॉपकिंस ब्लूमबर्ग स्कूल ऑफ पब्लिक हेल्थ ने. आइए जानते हैं कि यह सुपरबग क्या है? ये कितना खतरनाक है? इससे क्या दिक्कतें हो सकती हैं? (फोटोःगेटी)
साइंटिस्ट डॉ. अर्टुरो कासाडेवाल ने कहा कि इस सुपरबग का नाम है कैंडिडा ऑरिस (Candida Auris). इसे सबसे पहले करीब एक दशक पूर्व खोजा गया था. लेकिन आजतक ये रहस्य ही है कि ये आया कहां से है. उसकी उत्पत्ति कहां से हुई है. डॉ. अर्टुरो कासाडेवाल जॉन्स हॉपकिंस ब्लूमबर्ग स्कूल ऑफ पब्लिक हेल्थ के मॉलीक्यूलर माइक्रोबायोलॉजी एंड इम्यूनोलॉजी विभाग के प्रमुख हैं. इस स्टडी को करने वाली टीम में कई भारतीय साइंटिस्ट्स भी शामिल हैं. (फोटोःगेटी)
कैंडिडा ऑरिस (Candida Auris) को सबसे पहले साल 2009 में जापान के एक मरीज में खोजा गया था. यह एक तरह का कवक (Fungus) है. इसके बाद यह पूरी दुनिया में फैल गया. यह एक बार में तीन महाद्वीपों पर दिखाई दिया था. जिसकी वजह से दुनियाभर के वैज्ञानिक परेशान हो गए थे. (फोटोःगेटी)
सेंटर्स फॉर डिजीस कंट्रोल एंड प्रिवेंशन (Centers For Disease Control and Prevention - CDC) के मुताबिक कैंडिडा ऑरिस (Candida Auris) माइक्रोब की वजह से खून से संबंधित गंभीर संक्रमण हो सकता है. खास तौर से उन मरीजों को जिन्हें कैथेटर्स (मूत्रनली), फीडिंग ट्यूब्स (खाने की नली) या ब्रीदिंग ट्यूब्स (सांस लेने की पाइप) लगी हों. (फोटोःगेटी)
कैंडिडा ऑरिस (Candida Auris) का इलाज इसलिए मुश्किल है क्योंकि ये कई एंटीफंगल दवाओं से बच जाता है. यानी इस पर कई एंटीफंगल दवाओं का असर नहीं होता. इतना ही नहीं ये कोरोनावायरस की तरह किसी भी तरह के पर्यावरणीय सतह पर कई दिनों तक रह सकता है. डॉ. कासाडेवाल ने कहा कि अगर यह अस्पताल में पहुंच जाए तो प्रलय ला देता है. (फोटोःगेटी)
Deadly hospital superbug found on a remote island beach https://t.co/bSKce3o9D0 pic.twitter.com/YLaL7gcRaM
— Live Science (@LiveScience) March 16, 2021
इस सुपरबग की अन्य प्रजातियां पौधों और जलीय पर्यावरण में भी पाई जाती हैं. डॉ. कासाडेवाल और उनकी टीम ने पाया कि क्लाइमेट चेंज होने की वजह से कैंडिडा ऑरिस (Candida Auris) ज्यादा तापमान और उमस भरे इलाके में रहने के लायक बन गया है. जंगलों आदि में पनपने लगा है. इंसानों के शरीर में इसका विकास तेजी से होता है क्योंकि इसे पर्याप्त गर्म तापमान मिलता है. (फोटोःगेटी)
कैंडिडा ऑरिस (Candida Auris) पर हुए इस खुलासे से प्रेरित होने के बाद दिल्ली यूनिवर्सिटी की मेडिकल माइकोलॉजिस्ट डॉ. अनुराधा चौधरी और उनकी टीम ने अंडमान द्वीप के दूरस्थ द्वीपों और भारत व म्यांमार के बीच स्थित द्वीपों के 8 अलग-अलग स्थानों से मिट्टी और पानी की जांच की. इन लोगों ने कैंडिडा ऑरिस (Candida Auris) के सैंपल नमक वाले वेटलैंड (जहां आमतौर पर इंसान नहीं जाते) और आम तटों से अलग-अलग कलेक्ट किया. (फोटोःगेटी)
डॉ. अनुराधा चौधरी की टीम ने पाया कि तटों से प्राप्त कैंडिडा ऑरिस (Candida Auris) के सैंपल मल्टीड्रग रेसिसटेंट हैं. यानी इन पर कई एंटीफंगल दवाइयों का असर नहीं होता. ऐसे ही सैंपल अस्पतालों में एक दशक पहले मिले थे. जबकि, वेटलैंड्स से मिले सैंपल अलग थे. इन पर दवाओं का असर होता है. ये धीमे-धीमे फैलते हैं. जबकि तटों पर मिलने वाले कैंडिडा ऑरिस फंगस तेजी से फैलते हैं. (फोटोःगेटी)
इस सैंपल से पता चला कि जिस सैंपल से इंसानों समेत कई स्तनधारी जीवों को खतरा है वो खुले में घूम रहा है. ये एक खतरनाक संदेश है. डॉ. कासाडेवाल ने कहा कि इस स्टडी से ये पता चला है कि वैश्विक स्तर पर बढ़ रहा तापमान भविष्य में हमारे लिए कई तरह के खतरे लेकर आ रहा है. (फोटोःगेटी)
हालांकि, इस स्टडी से इस बात का खुलासा नहीं हुआ है कि कैंडिडा ऑरिस (Candida Auris) फंगस अंडमान और निकोबार द्वीप समूह पर प्राकृतिक रूप से वास करता है. या यहीं पर पैदा हुआ है. ये संभव है कि कैंडिडा ऑरिस (Candida Auris) माइक्रोब यहां पर इंसानों के जरिए आया हो. खासतौर पर तटों से जहां इंसानी गतिविधियां काफी ज्यादा होती हैं. इसके बाद ये माइक्रोब इंसानी मल से निकलकर समुद्री लहरों के जरिए अन्य द्वीपों पर फैला होगा. (फोटोःगेटी)
इस नए अध्ययन से उम्मीद जताई जा रही है कि अब वैज्ञानिक कैंडिडा ऑरिस (Candida Auris) पर और अधिक अध्ययन करना होगा. इस माइक्रोब को लेकर प्रयोगशालाओं में रिसर्च करनी होगी. इनपर असर करने वाली दवाएं बनानी होंगी ताकि अगर ये महामारी का रूप ले तो इसे खत्म किया जा सके. या फिर इसकी संक्रामकता को कम किया जा सके. (फोटोःगेटी)
डॉ. कासाडेवाल ने माना और जोर दिया कि ग्लोबल वार्मिंग की वजह से कैंडिडा ऑरिस (Candida Auris) इंसानों में प्रवेश करने की क्षमता को विकसित कर चुका है. हमारे पास इसका सही इलाज नहीं है. अगर इसी तरह और वायरस, बैक्टीरिया या माइक्रोब तापमान का सहारा लेकर इंसानों या अन्य जीवों को संक्रमित करते रहे तो ये बेहद खतरनाक होगा. (फोटोःगेटी)
डॉ. कासाडेवाल ने कहा कि अगर हमारी स्टडी को प्रामणिकता और अंतरराष्ट्रीय स्तर पर मान्यता मिलती है तो हम दुनिया के अन्य स्थानों से भी सैंपलिंग करके कैंडिडा ऑरिस (Candida Auris) की वर्तमान हालात का पता लगाएंगे. (फोटोःगेटी)
साल 2009 से 2011 के बीच दिल्ली के दो अस्पतालों से 12 कैंडिडा ऑरिस (Candida Auris) आइसोलेट किए गए थे. साल 2016 तक कई दक्षिण एशियाई देशों में ये माइक्रोब फैल गया. अक्टूबर 2016 में ये लंदन के रॉयल ब्रॉम्प्टन हॉस्पिटल में मिला. 2017 में अमेरिका में इसके 77 मामले सामने आए थे. इनमें से 69 तो न्यूयॉर्क और न्यूजर्सी के थे. (फोटोःगेटी)
अप्रैल 2019 में CDC ने इस माइक्रोब के हमले की लिस्ट बनाई. पता चला कि ऑस्ट्रेलिया, ऑस्ट्रिया, बेल्जियम, कनाडा, चीन, कोलंबिया, फ्रांस, जर्मनी, भारत, इरान, इजरायल, जापान, केन्या, कुवैत, मलेशिया, मेक्सिको, नीदरलैंड्स, नॉर्वे, ओमान, पाकिस्तान, पनामा, रूस, सऊदी अरब, सिंगापुर, साउथ अफ्रीका, साउथ कोरिया, स्पेन, स्विट्जरलैंड, ताइवान, यूएई, यूके, अमेरिका और वेनेजुएला में कैंडिडा ऑरिस (Candida Auris) ने लोगों को संक्रमित किया है. (फोटोःगेटी)
इस समय कैंडिडा ऑरिस (Candida Auris) के इलाज या रोकथाम के लिए कोई वैक्सीन विकसित नहीं हुई है. हालांकि चूहे में NDV-3A नाम की ट्रायल वैक्सीन का सफल परीक्षण किया जा चुका है. इस वैक्सीन की वजह से चूहे में फंगस के खिलाफ प्रतिरोधक क्षमता भी विकसित हुई लेकिन इसका परीक्षण अभी तक इंसानों पर नहीं हुआ है. (फोटोःगेटी)